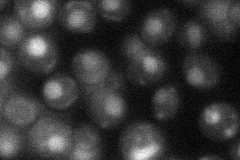
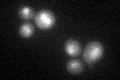
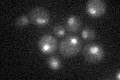

View description
Ribosomal lysine methyltransferase specific for monomethylation of Rpl42ap and Rpl42bp (lysine 40); nuclear SET domain containing protein
Localization:
Intensity:
Fold change:
Significance:
-
C’ GFP library in SD

nucleus25.18 -
N' NOP1pr-GFP in SD

nucleus107.885 -
N' TEF2pr-mCherry in SD

nucleus0 -
N' NATIVEpr-GFP in SD
nucleus30.5979 -
N' TEF2pr-VC and Cyto-VN in SD

nucleus49.0396 -
C’ GFP library in SD+DTT
nucleus24.740.98No -
C’ GFP library in SD+H2O2

nucleus25.51.01No -
C’ GFP library in Starvation Media
nucleus21.540.85No -
C’ GFP library on the background of Pup2-DaMP

nucleus -
C’ GFP library on the background of CCT mutant

nucleus27.83891.10527No
